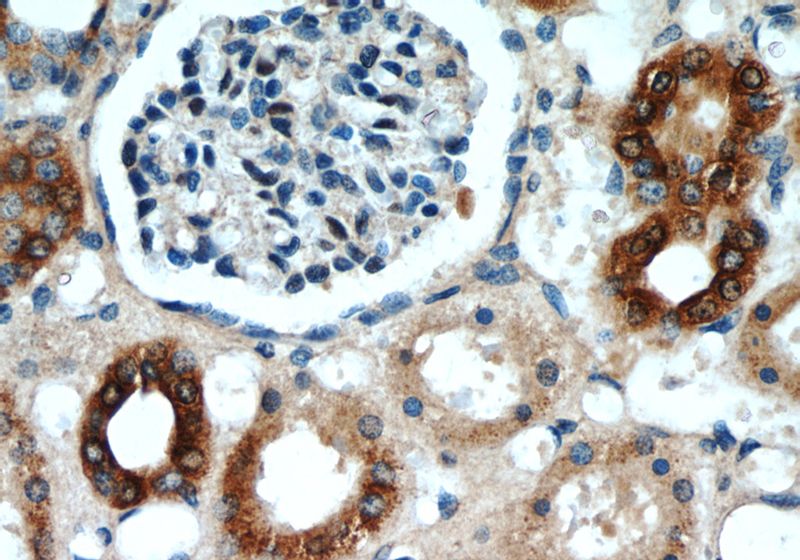
Immunohistochemistry of paraffin-embedded human kidney slide using Catalog No:108058(ANGPTL4 Antibody) at dilution of 1:50

-
Product Name
ANGPTL4 antibody
- Documents
-
Description
ANGPTL4 Rabbit Polyclonal antibody. Positive WB detected in HEK-293 cells, mouse heart tissue. Positive IP detected in mouse heart tissue. Positive IHC detected in human kidney tissue, human heart tissue, human ovary tissue. Positive IF detected in NIH/3T3 cells, HEK-293 cells. Observed molecular weight by Western-blot: 45-50 kDa
-
Tested applications
ELISA, IHC, IF, IP, WB
-
Species reactivity
Human, Mouse; other species not tested.
-
Alternative names
angiopoietin like 4 antibody; Angiopoietin like protein 4 antibody; Angiopoietin related protein 4 antibody; ANGPTL2 antibody; ANGPTL4 antibody; ARP4 antibody; FIAF antibody; HFARP antibody; NL2 antibody; PGAR antibody; pp1158 antibody; PSEC0166 antibody; UNQ171/PRO197 antibody
-
Isotype
Rabbit IgG
-
Preparation
This antibody was obtained by immunization of ANGPTL4 recombinant protein (Accession Number: NM_139314). Purification method: Antigen affinity purified.
-
Clonality
Polyclonal
-
Formulation
PBS with 0.1% sodium azide and 50% glycerol pH 7.3.
-
Storage instructions
Store at -20℃. DO NOT ALIQUOT
-
Applications
Recommended Dilution:
WB: 1:200-1:2000
IP: 1:200-1:2000
IHC: 1:20-1:200
IF: 1:20-1:200
-
Validations

Immunohistochemistry of paraffin-embedded human kidney slide using Catalog No:108058(ANGPTL4 Antibody) at dilution of 1:50
Immunohistochemistry of paraffin-embedded human kidney slide using Catalog No:108058(ANGPTL4 Antibody) at dilution of 1:50

HEK-293 cells were subjected to SDS PAGE followed by western blot with Catalog No:108058(ANGPTL4 Antibody) at dilution of 1:600

IP Result of anti-ANGPTL4 (IP:Catalog No:108058, 4ug; Detection:Catalog No:108058 1:500) with mouse heart tissue lysate 4000ug.

Immunofluorescent analysis of NIH/3T3 cells using Catalog No:108058(ANGPTL4 Antibody) at dilution of 1:50 and Alexa Fluor 488-congugated AffiniPure Goat Anti-Rabbit IgG(H+L)
-
Background
Angiopoietin-like protein 4 (ANGPTL4), a member of the angiopoietin-like protein subfamily, is a secretory protein that functions as an important modulator of glucose and lipid metabolism. ANGPTL4 inhibits lipoprotein lipase (LPL)-dependent lipolysis thereby limiting the uptake of free fatty acids. Overexpression of ANGPTL4 results in hypertriglyceridemia, while ANGPTL4 deficiency suppresses foam formation in macrophages and protects against atherosclerosis. ANGPTL4 may play a role in several cancers and it also has been shown to prevent the metastatic process by inhibiting vascular activity as well as tumor cell motility and invasiveness. Decreased expression of this protein has been associated with type 2 diabetes.
-
References
- Sato M, Kadota M, Tang B. An integrated genomic approach identifies persistent tumor suppressive effects of transforming growth factor-β in human breast cancer. Breast cancer research : BCR. 16(3):R57. 2014.
Related Products / Services
Please note: All products are "FOR RESEARCH USE ONLY AND ARE NOT INTENDED FOR DIAGNOSTIC OR THERAPEUTIC USE"
